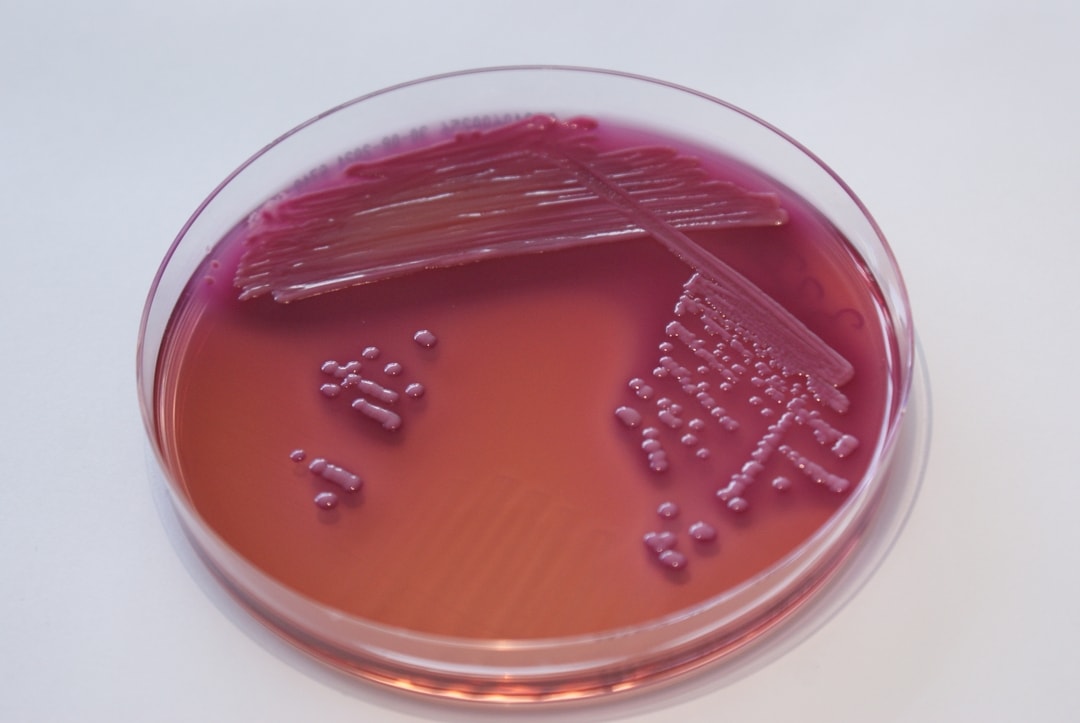

Kapotte en pijnlijke mondhoeken bij patiënten is ons geen van allen vreemd. Cheilitis angularis is een vaak voorkomende diagnose. Cheilitis angularis is een onsteking van de mondhoek(-en), gekenmerkt door fissuurvorming, maceratie en erytheem van de lippen en de aangrenzende huid. Veel voorkomende veroorzakers zijn Candida albicans en Staphylococcus aureus, waardoor de behandelprotocollen hierop gebaseerd zijn. Naast Candida albicans en Staphylococcus aureus zijn er meerdere pathogenen die Cheilitis angularis kunnen veroorzaken. Onderstaand artikel is een case report van een patiënt waarbij een gram negatieve bacterie is aangetoond. Microbiologisch onderzoek heeft hierbij waardevolle informatie gegeven en heeft tot een patiënt-specifieke behandeling geleid.
Heeft u ook een onopgeloste casus en wilt u microbiologisch verder kijken neem dan contact met ons op.
Het hele artikel kunt u hieronder lezen vanaf pagina 46.
https://issuu.com/dentista-magazine/docs/21dentista04_-_magazine

.png)